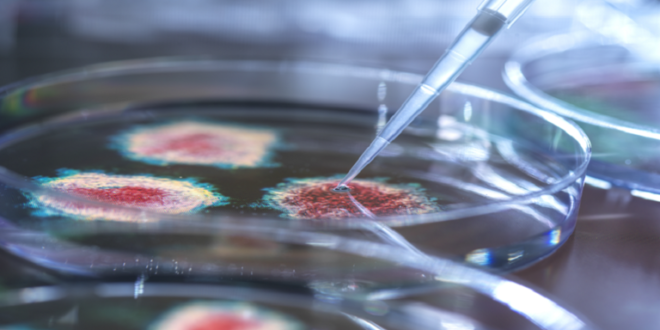

منبر العراق الحر :
كشف باحثو معهد ملبورن الملكي للتكنولوجيا (RMIT) في أستراليا عن مادة سيليكون مطورة حديثا مغطاة بمسامير نانوية، تعمل على تفكيك جزيئات الفيروس أو إتلافها لمنع تكاثرها.
وقال الباحثون إنه يمكن استخدامها في المستشفيات ومختبرات العلوم، وفي أي مكان تحتاج فيه الأسطح إلى التعقيم قدر الإمكان، حيث تقضي المادة (التي يمكن تغليف الأسطح بها) على النشاط الفيروسي بنسبة 96% خلال 6 ساعات.
وأوضحوا أن هذه النسبة ستكون كافية لحماية معظم الأفراد الأصحاء من مجموعة من مسببات الأمراض.
وأوضح فريق البحث أن نهجهم الجديد مستوحى من الطبيعة، فالحشرات، بما في ذلك اليعسوب والزيز، لديها نتوءات نانوية على أجنحتها، والتي يمكن أن تدمر البكتيريا والفطريات.
وأنشأ الباحثون مادة بنتوءات يبلغ ارتفاعها 290 نانومترا فقط، وبأطراف تبلغ سماكتها 2 نانومتر (أرق 30000 مرة من شعرة الإنسان).
وتقول ناتالي بورغ، عالمة الأحياء الجزيئية في RMIT: “تبدو المادة السطحية القاتلة للفيروسات وكأنها مرآة سوداء مسطحة للعين المجردة، ولكنها تحتوي على نتوءات صغيرة مصممة خصيصا لقتل الفيروسات. ويمكن دمج هذه المادة في الأجهزة والأسطح لمنع انتشار الفيروس وتقليل استخدام المطهرات”.
وإذا أمكن توسيع نطاق هذه المادة السطحية وتطبيقها في بيئات الرعاية الصحية، فقد تحدث فرقا كبيرا.
نشر البحث في مجلة ACS Nano.
المصدر: ساينس ألرت
 منبر العراق الحر منبر العراق الحر
منبر العراق الحر منبر العراق الحر